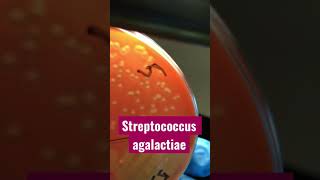

ПОЧЕМУ НА ЖИВОТЕ НЕТ ПОЛОСКИ ПРИ БЕРЕМЕННОСТИ
Одним из характерных симптомов беременности часто является полоска на животе, известная как беременная полоска или линия нигры. Однако она не всегда появляется у всех женщин во время беременности. Почему так происходит?
На животе может отсутствовать полоска при беременности по разным причинам. Во-первых, это может быть обусловлено наследственными факторами. Женщины с более темной кожей часто имеют меньше шансов увидеть полоску на своем животе. Во-вторых, колебания уровня гормонов также могут влиять на появление полоски. Если уровень меланина, пигмента, отвечающего за цвет кожи, низок, то полоска может не быть видна. Кроме того, индивидуальные особенности кожи и гормональное состояние каждой женщины могут также влиять на наличие или отсутствие полоски.
Степень видимости полоски также может изменяться в течение беременности. У некоторых женщин полоска может проявиться только во втором или третьем триместре, когда уровень гормонов стабилизируется. У других она может быть менее выражена или даже исчезнуть после родов.
Важно помнить, что отсутствие полоски на животе не является проблемой или признаком проблемы во время беременности. Появление или отсутствие полоски не связано с здоровьем ребенка или матери. Если у вас возникают вопросы или беспокойства, всегда консультируйтесь со своим врачом.
ТЕМНАЯ ПОЛОСА НА ЖИВОТЕ ВО ВРЕМЯ БЕРЕМЕННОСТИ - Причины пигментации кожи на животе беременной
🔎 Вторая полоска слабая. Это беременность❓
⭕ Боли при беременности в первом триместре
Темная полоска на животе во время беременности
🤰 Тянущие боли внизу живота при беременности
ТЕМНАЯ ПОЛОСА НА ЖИВОТЕ ВО ВРЕМЯ БЕРЕМЕННОСТИ - Почему возникает темная полоска и что с ней делать
ПОЛОСКА НА ЖИВОТЕ ВО ВРЕМЯ БЕРЕМЕННОСТИ - Когда появляется темная полоска и что означает
ПОЛОСКА НА ЖИВОТЕ ВО ВРЕМЯ БЕРЕМЕННОСТИ - На каком сроке проявляется полоска на животе у беременных
ТЁМНАЯ ПОЛОСКА НА ЖИВОТЕ ВО ВРЕМЯ БЕРЕМЕННОСТИ / Почему появилась темная полоска на животе?
Почему появляется темная полоска на животе при беременности